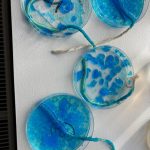

We had a fun filled week of activities as part of Science Week 2024 including a riddle competition for the whole school, various experiments and investigations in all science classes and special thanks to Benny Joyce who delivered informative workshops on water pollution and microplastics. Thank you to the science department and well done to the students who were winners in the competition
Share this: